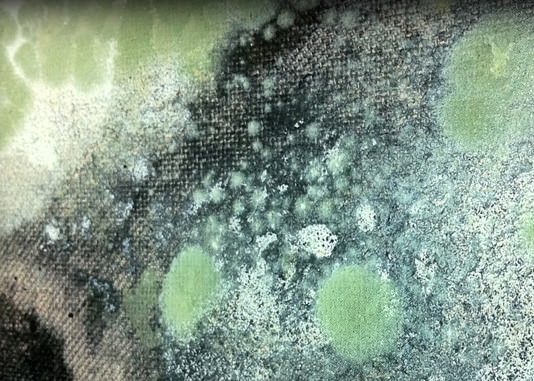

Create an account
Welcome! Register for an account
La password verrà inviata via email.
Recupero della password
Recupera la tua password
La password verrà inviata via email.
-
- container colonna1
- Categorie
- #iorestoacasa
- Agenda
- Archeologia
- Architettura
- Arte antica
- Arte contemporanea
- Arte moderna
- Arti performative
- Attualità
- Bandi e concorsi
- Beni culturali
- Cinema
- Contest
- Danza
- Design
- Diritto
- Eventi
- Fiere e manifestazioni
- Film e serie tv
- Formazione
- Fotografia
- Libri ed editoria
- Mercato
- MIC Ministero della Cultura
- Moda
- Musei
- Musica
- Opening
- Personaggi
- Politica e opinioni
- Street Art
- Teatro
- Viaggi
- Categorie
- container colonna2
- Servizi
- Sezioni
- container colonna1
GALLERIA ZAK
Indirizzo
Monteriggioni, Piazza Roma, 13, (Siena)
Sito web
Telefono biglietterie
+39 3469437211
Email
infogalleriazak@gmail.com
LE MOSTRE E GLI EVENTI OSPITATI DA QUESTA SEDE
TUTTIIN CORSOCONCLUSIFUTURI
NETWORK SEDE